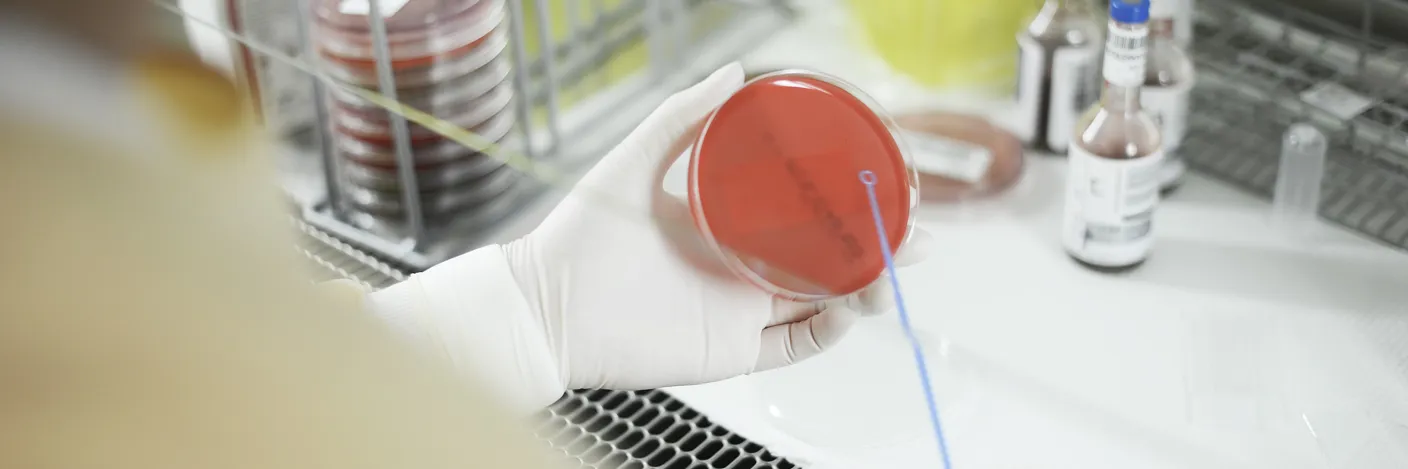
Hender jobber med laboriatorieutstyr

Kontakt
Sentralbord
Postadresse
Helse Fonna HF
Postboks 2170
5504 Haugesund
E-post
Sikker dialog
EDialog – eit sikkert og godt alternativ til e-post
Om du har spørsmål eller tilbakemeldingar som inneheld sensitiv informasjon, brukar du eDialog. Det er ein sikker kanal for å sende oss informasjon som er underlagt teieplikt. Du kan eventuelt sende brev i posten.
Slik finn du fram
Oppmøtestad
Laboratoriet i Haugesund: du finn oss i 4. etasje i sydvestre blokk på Haugesund sjukehus. Vi har opent kvardagar kl. 08.00-14.30. Torsdagar har vi stengt frå 11.00-11.45.
Laboratoriet på Stord: du finn oss i 1. etasje på Stord sjukehus. Våre opningstider er kvardagar kl. 08.00-14.30.
Laboratoriet i Odda: Du finn oss i underetasjen (U-etasje) på Odda sjukehus. Våre opningstider er kvardagar kl. 09.00-14.00.

Haugesund sjukehus
Karmsundgata 120, 5528 Haugesund

Stord sjukehus
Tysevegen 64, 5416 Stord

Odda sjukehus
Sjukehusvegen 10, 5750 Odda